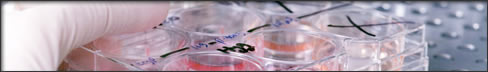
Laboratório

Nossos Serviços
Laboratório
Possuímos laboratório altamente preparado para atender as necessidades de nossos clientes, com tecnologia de última geração, para atendimento de análises físico químicas e microbiológicas.
Realizamos um extensa gama de análises em diferentes produtos, como segue:
- Açúcar
- Cereais
- Soja
- Trigo e outros
- Alcool
- Fertilizantes e Materias Primas
- Metais e Minerais
- Alimentos Industrializados
Contamos com profissionais altamente qualificados, formados nas melhores Universidades do País.
Caso nossos clientes necessitem, montamos um projeto específico com acompanhamento e monitoramento de amostragem e análises.
Mantemos convênio com Universidades em Território Nacional para análises de contra-prova caso necessário.
Somos Membros de Organizações Internacionais, como :
- GAFTA ( Grain and Feed Trade Association );
- FOSFA ( Federation of Oilseeds and Fats Association );
- SAL ( Sugar Association of London );
- GENETIC I.D.;
- Syndicar Du Commerce Des Grains de Paris;
- European CEE Accreditation for Proof of Arrival Certificate;
- ISO 9001-2000 Certified.

copyright © 2008 S.I.C.E.A - Todos os direitos reservados
Reservas e Direito
© Todos os direitos reservados à Sicea International do Brasil Ltda . Este material não pode ser publicado, transmitido por broadcast, reescrito ou redistribuído sem prévia autorização.
